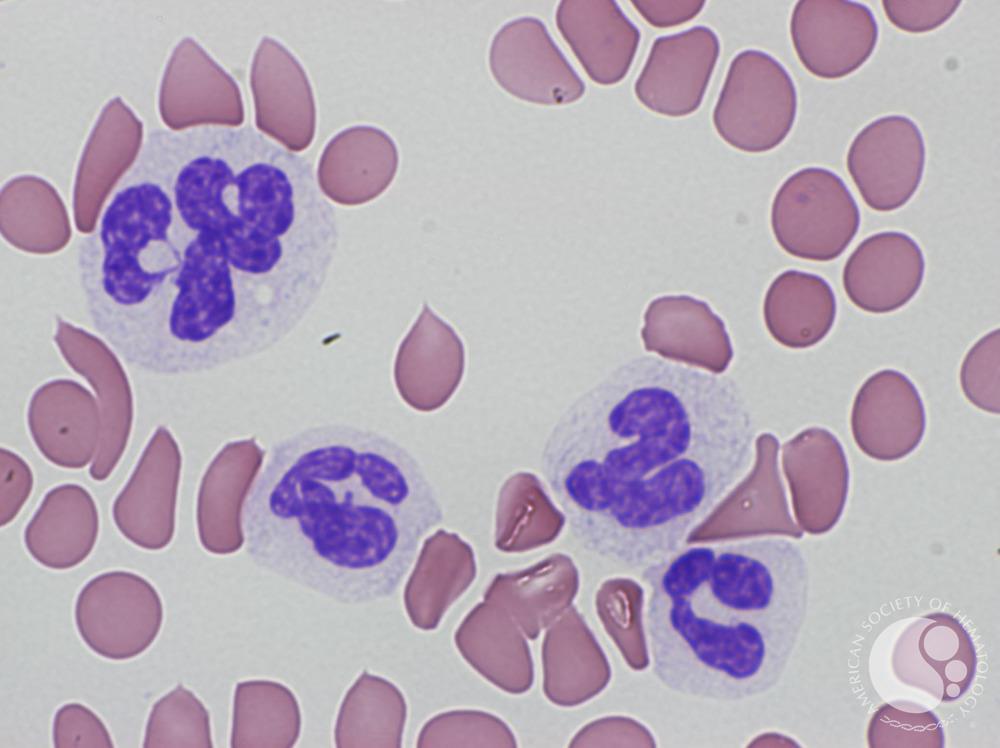

Researchers from Bulgaria conduct an analysis of the potential for therapeutic vaccines in by comparing testing results for patients from their country with an international data set.
Despite their status as myeloid malignancies, myeloproliferative neoplasms (MPNs) have drawn interest from researchers as candidates for therapeutic vaccines. Giroux et al drew attention in Science in 2022 by investigating MPNs with calreticulin (CALR) mutations, which lack T cells to target this antigen.1 Specifically, Giroux’s team pursued the major histocompatibility complex (MHC-1) allele frequences they observed and developed a heteroclitic peptide vaccine to activate T cells against tumors.
Now, a team from Bulgaria follows Giroux with a statistical approach, with results appearing in Frontiers in Immunology.2 The group first made comparisons between patients with MPNs and healthy controls within the homogenous population of Bulgaria before completing a meta-analysis involving patients and healthy controls from the 1000 Genomes Project, an international effort to collect human genome samples.3
Myeloproliferative neoplasms have drawn interest from researchers as candidates for therapeutic vaccines | Image credit: © Ruimin Li; Xiaoqiang Lian for ASH Image Bank
To start, the team established that human leukocyte antigen class I (HLA-I) and class II (HLA-II) alleles alter how JAK2 V617F and CALR mutations create cancer cells in MPNs, but that the role of immune response in MPNs is not well known. Thus, the team sought to explore the role of HLA genes in MPNs with CALR mutations. They conducted analyses involving 42 patients with CALR mutations and 158 with JAK2 V6127F mutations, as well as 1083 healthy controls.2
As the authors explained, mutations in 3 genes drive all MPNs; they are JAK2, CALR, and MPL. “These mutations originate at the level of hematopoietic stem cells, but, depending on the intrinsic and extrinsic factors, can lead to differential skewing of hematopoiesis predominantly into one of the myeloid lineages presenting clinically with 1 of the 3 phenotypes,” which they noted are essential thrombocythemia, polycythemia vera, and primary myelofibrosis.2
Mutations may appear just as cancer cells form but also before symptoms appear, in a status called clonal hematopoiesis of indeterminate potential, or CHIP; it may take a long time for CHIP to convert to malignancy, and different mutations follow different paths.
How quickly the conversion happens varies, and “The putative role of immune surveillance as a significant contributor to early oncogenesis in MPNs is becoming increasingly recognized,” the authors state.
Understanding the roles of the mutations, when they appear, “have practical implications for the development of neoantigen-based vaccines in MPNs.”2
“A global analysis of the diversity of HLA-I genotypes revealed no significant differences” between patients with CALR [mutations] and controls," the authors wrote. However, they found that a single HLA-I allele, known as C*06:02, “showed an inverse correlation with presence of CALR mutation.”2
As the study revealed, however, this will not be a straightforward process.
The analysis. The authors described in detail their process for performing in vitro measurements of antigen-specific Т-cell immune response against CALR and JAK2 mutant proteins and for performing assays for multiple HLA alleles and 2 CALR peptides. Investigators extracted genomic DNA from blood samples of Bulgarian patients with known or suspected MPNs for diagnostic testing, using next-generation sequencing, and clinical management. Samples and tests were also obtained for healthy controls.2
The team retrieved HLA-1 genotype data from other studies involving Italian and Austrian patients, a Danish cohort provided by Giroux et al, and data from 2 US academic centers. These data were used to calculate HLA evolutionary divergence (HED) in the data from the Bulgarian patients, who were considered genetically similar. The team calculated HED and patient harmonic mean best rank (PHBR), using data from 2618 subjects included in the 1000 Genomes Project. PHBR is a metric that evaluates a patient’s ability to present a specific mutation to the immune system.
“HED is a measure of the structural divergence of HLA alleles in heterozygous individuals; by definition, it is zero for homozygous individuals. Individuals with higher values of HED have more structurally divergent HLA molecules encoded by heterozygous HLA loci,” the authors wrote. “Therefore, the higher the HED, the more likely it is that the individual can present more antigens through the HLA molecules encoded by a given locus. Tumors in individuals with higher HEDs can potentially be more immunogenic, as evidenced recently by the reported better response to immune checkpoint inhibitors in patients with higher HED values for some alleles.”
Results. Evaluations found evidence of specific T cells for neoantigens from both CALR and JAK2 V617F mutant peptides in healthy controls, but not in the patients with MPNs. The authors say this suggests that CALR mutations are immunogenic, so they tested to learn if the identified neoantigens could bind to specific HLA-1 molecules with a standardized assay. This “did not reveal any binding affinity” of the 2 peptides to the 4 tested HLA-1 conformers, and could not alone be used as evidence to determine immunogenicity potential of neoantigens.2
That said, studies show both CALR and JAK2 V617F undergo a number of changes during development, “which is consistent with the idea that, in many cases, driver cancer mutations are HLA-I and HLA-II restricted.”2
In addition, the authors write, the results show HLA-1 genotype PHBRs “are much lower” for CALR mutations than for JAK2 V617F, that CALR mutations could be significantly degraded by proteasome, “and the derived peptides could bind to transport proteins TAP1 and TAP2.”
Conclusions. The challenge, the authors write, is that while CALR mutations theoretically could lead to generation of neoantigens in vivo, based on the assays conducted in this study, no conclusions can be drawn on how well they can be produced in vitro.
“Collectively, these findings confirm that CALR [mutations are] not only antigenic but also sufficiently immunogenic at least in people with an intact immune system. However, based on our assay, no definitive conclusions can be drawn regarding the frequency of healthy individuals who may possess existing T cells that recognize CALR [mutation]–derived neoantigens in the context of specific HLA-I molecules.”2
The authors explored several explanations for the behavior of different mutations over time, from JAK2 mutations appearing early to CALR mutation appearing later, to the different roles that HLA-I and HLA-II play in the behavior of CALR. They highlight just how tricky developing a vaccine might be given the timing of when mutations appear.
“The HLA-I–mediated restriction of CALR [mutation]–driven oncogenesis suggests that it might be unlikely to obtain clinically meaningful responses with peptide vaccine based on the mutated CALR sequence,” the study authors wrote, noting that Giroux’s team reached the same conclusion.
Any vaccine in MPNs will require much more research, they concluded.
“We propose that an additional approach, which could be explored, would be testing of endogenous TAP-independent peptides as potential targets for development of vaccines in MPNs. An alternative approach could also be to target neoantigens from atypical transcripts or endogenous retroviruses,” they wrote. “Ideally, any design of neoantigen-based vaccine in MPNs should be supplemented by HLA-I and -II ligandome data potentially in combination with immune checkpoint inhibitors or recombinant interferons.”
References
1. Giroux M, Holmström MO, Zappasodi R, et al. Calreticulin mutant myeloproliferative neoplasms induce MHC-I skewing, which can be overcome by an optimized peptide cancer vaccine. Sci Trans Med. 2022;14(649):eaba4380. doi:10.1126/scitranslmed.aba4380
2. Shivarov V, Tsvetkova G, Micheva I, et al. Differential modulation of mutant CALR and JAK2 V617F-driven oncogenesis by HLA genotype in myeloproliferative neoplasms. Front Immunol. Published online September 16, 2024. doi:10.3389/fimmu.2024.1427810
3. 1000 Genomes Project. The International Genome Sample Resource. Accessed September 18, 2024. https://www.internationalgenome.org/1000-genomes-summary/